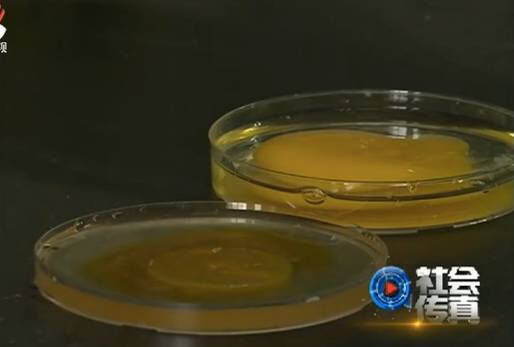
人造鸡蛋真假难辨,人造假鸡蛋

鸡蛋营养丰富、价格便宜,是不少人的最爱。再加上多年来健康饮食观念深入人心,每天一个蛋成了很多人的饮食习惯。不过,这常见的鸡蛋有时候却会出现不寻常的现象。例如,有的网友说,市场上买的鸡蛋个头、大小都一样,怀疑是人造的;还有的网友说,鸡蛋煮熟后,蛋黄居然像橡皮,一定有问题。那么,这些现象都是真的吗?现在真的有人造鸡蛋在市场上售卖吗?

这是一段在国外社交网站非常火的视频。发帖人杰罗姆称,他在咖啡店点到的这份鸡蛋,蛋黄异常硬,蛋白还像水。并配文字称“每个人都注意了,假鸡蛋来了新加坡!”。短短3天该帖就被转发5000多次,超过26万人进行观看。随后,新加坡农粮局展开调查,结果发现,此事纯属造谣。发帖人杰罗姆随后*帖删**,并辩称,此举只是为了提高人们的警惕。
此事虽然已经过去,但网友却并不消停。不久,更多的网友发布了更多视频来证实“人造鸡蛋”的存在。例如,在这段仅有5秒的视频中,一位工人正熟练地把白色胶状物质装入椭圆形容器中,从桌上堆放的成品来看,工人正在制造的东西和鸡蛋非常像。对此,有网友表示,再也不吃鸡蛋了!

不过,也有眼尖的网友留言,说视频中的工人只不过在制造一种以沙皮胶为主要原料的整蛊玩具,并非人造鸡蛋。
在网页上搜索人造鸡蛋,相关的新闻还真不少。例如这段视频中,一位操着泉州口音的男子称在当地超市买到了橡皮鸡蛋。
网友:大家来看一看,鸡蛋、鸡蛋,超市买的鸡蛋。今早上刚卤的,还能跳的。

家住重庆的陈女士也碰到了此类事情。把从市场上买来的鸡蛋放到锅里煮之后,就发现不对劲,把鸡蛋剥开,里面的蛋黄十分结实。
重庆市民 陈女士:它不圆,有弹性。颜色都不一样, 捏不烂。
在这段视频中,网友也表示可能买到了假鸡蛋。
网友:这个黄你看,它都不带散的。 它是整个一个个,都是这样的。你看这鸡蛋,这就是那种假鸡蛋,。

更夸张的是,除了视频外,网络上还流传不少人造鸡蛋的制作方法。那么,真的有人造鸡蛋吗?记者找到南昌大学化工学院研究员,请他与我们一起,按照网上介绍的方法完成“人造鸡蛋”的制作过程。
记者准备了海藻酸钠、氯化钙以及柠檬黄。首先将水加热,并加入适量海藻酸钠。不断搅拌,最后溶液呈现半透明、粘稠状。
接下来,将一部分海藻酸钠溶液用柠檬黄调色。调色后将它倒入球形容器,并放入氯化钙溶液中静置1分钟。
最后一步,则是把两者拼起来,这样一个人造鸡蛋的制作就完成了。
不得不说,人造鸡蛋在外观上和真的鸡蛋确实有几分相似。真蛋清和人造蛋清一样都是粘粘的。不过,真蛋黄一戳就会破,蛋黄迅速和蛋清融合在一起,人造蛋黄则更有韧性。那么,网络视频当中那些能跳的橡皮蛋就是这样被人造出来的吗?
南昌大学化工学院研究员 刘巍巍:从成本角度来看不可能。从拟真角度来看难度太大。
记者了解到,现在市面上的鸡蛋大约两三块钱一斤,每枚不到1块钱。算上材料、人工、设备、厂房等投入,一枚人造鸡蛋的成本远远高于真鸡蛋的售价。而且,真假鸡蛋很容易分辨,几乎没有市场。对此,江西省农业科学院从事家禽的遗传育种工作的武艳平博士认为。
江西省农业科学院畜牧研究所 武艳平:人造鸡蛋不可能存在。
那么,网络视频中的那些橡皮蛋又该怎么解释呢?专家认为,这和养殖场使用的饲料以及鸡蛋的储存方法有关。例如,棉籽饼粕的蛋白质含量很高,是畜牧业的饲料来源之一。但是,棉籽饼粕中的棉酚蛋白则会使蛋黄变色、变弹。另外,如果鸡蛋在煮之前低温储藏时间过长甚至冰冻过,导致蛋黄里的蛋白质变性,也容易出现橡皮蛋的情况。

为了验证专家这一观点,记者从市场上买来同一批次鸡蛋进行试验。首先将鸡蛋分成两份,一份常温放置,而另一份则放置在冷冻室。一天后,分别将两种鸡蛋煮熟。结果,常温放置的鸡蛋黄一捏就散开,而冷冻过的鸡蛋煮熟后,蛋黄真的出现了视频中那种情况。
其实人造鸡蛋的传言由来已久,早在2010年,央视就曾报道过国内有人以传授人造鸡蛋秘诀为幌子骗取培训费。时至今日,还没有人能在公开场合成功制造足以乱真的人造鸡蛋。目前而言,市面上的鸡蛋的确都是鸡生的,而不是什么人造的化工产品,老百姓大可放心。当然,专家也提醒说,鸡蛋人造的可能性虽然很小,但大家在食用鸡蛋时,也不能掉以轻心。在以往的新闻报道中,我们经常听到有人因为吃鸡蛋导致食物中毒。所以,挑选鸡蛋、存放鸡蛋甚至怎么吃鸡蛋也成了一门学问。

一般来说,如果购买的是超市里的盒装鸡蛋,只需要注意生产日期、保质期以及储藏方法就可以了。如果是购买散装鸡蛋,则要多方面判断。具体来说可以分为看、摸、听、水浸等。
相对于挑选,存放鸡蛋的讲究更多。曾有媒体报道,沈阳一家三口吃炒鸡蛋中毒,出现呕吐、高烧、腹泻症状,后送医院抢救。而原因竟是因为他们吃的鸡蛋在保存前被清洗过。由于蛋壳表面有一层保护膜,可以阻止细菌进入鸡蛋内部。而被清洗过的鸡蛋失去了保护,细菌就可以通过蛋壳上看不见的小孔进入内部,导致鸡蛋的腐败变质。
江西省农业科学院畜牧研究所 武艳平:鸡蛋储存的话最好不要洗,而且是干燥的时候放到那个保鲜膜里面把它封起来,有那个蛋托的话更好,把那个大头朝上放比较好。如果保存方法得当的话,在冰箱里面温度适宜的话一个月都没问题。

有关食物的谣言层出不穷,例如,这几天疯传的肉松饼里有棉花、前段时间的塑料紫菜等说法都曾引起轩然大波,让一些商家因为谣言损失巨大。同样,人造鸡蛋也是类似的谣言,引起不少人的担心。但其实,有些鸡蛋本身属于一种较为廉价的农产品,花费大力气去研究怎么人造是个亏本的买卖,这样的生意又有谁会去做呢?还是我们那句话,很多谣言稍加判断,就能不攻自破,大家不要盲目轻信。
(记者:袁权)
......
观看完整视频请点击左下角阅读原文
官方网站:http://www.jxntv.cn/
官方微信:jiangxiweishixinwen
江西卫视新闻各档栏目及收视时间
晨光新视界
播出时间:江西卫视每天早晨7:00
杂志天下
播出时间:江西卫视周一至周五中午12:40
社会传真
播出时间:江西卫视每天下午18:17
江西新闻联播
播出时间:江西卫视每晚18:30
重播时间:江西二套每晚22:30
热线电话:0791-88303324
江西新闻夜航
播出时间:江西卫视每晚23:45
热线电话:0791-88313333